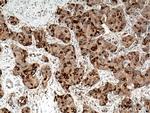
RRM1 Antibody in Immunohistochemistry (Paraffin) (IHC (P))
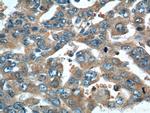
RRM1 Antibody in Immunohistochemistry (Paraffin) (IHC (P))

Search
Proteintech
RRM1 Polyclonal Antibody
{{$productOrderCtrl.translations['antibody.pdp.commerceCard.promotion.promotions']}}
{{$productOrderCtrl.translations['antibody.pdp.commerceCard.promotion.viewpromo']}}
{{$productOrderCtrl.translations['antibody.pdp.commerceCard.promotion.promocode']}}: {{promo.promoCode}} {{promo.promoTitle}} {{promo.promoDescription}}. {{$productOrderCtrl.translations['antibody.pdp.commerceCard.promotion.learnmore']}}
产品信息
10526-1-AP
种属反应
已发表种属
宿主/亚型
分类
类型
抗原
偶联物
形式
浓度
规格
纯化类型
保存液
内含物
保存条件
运输条件
产品详细信息
Immunogen sequence: IRNSLLIAP MPTASTAQIL GNNESIEPYT SNIYTRRVLS GEFQIVNPHL LKDLTERGLW HEEMKNQIIA CNGSIQSIPE IPDDLKQLYK TVWEISQKTV LKMAAERGAF IDQSQSLNIH IAEPNYGKLT SMHFYGWKQG LKTGMYYLRT RPAANPIQFT LNKEKLKDKE KVSKEEEEKE RNTAAMVCSL ENRDECLMCG S (593-792 aa encoded by BC006498)
靶标信息
RRM1 (Ribonucleotide reductase M1 polypeptide) is one of two non-identical subunits that constitute ribonucleoside-diphosphate reductase, an enzyme which catalyzes the biosynthesis of deoxyribonucleotides from the corresponding ribonucleotides. It provides the precursors necessary for DNA synthesis. RRM1 is involved in carcinogenesis, tumor progression.
仅用于科研。不用于诊断过程。未经明确授权不得转售。
生物信息学
蛋白别名: R RRM 1; RI RI RR 1; Ribonucleoside-diphosphate reductase large subunit; Ribonucleoside-diphosphate reductase subunit M1; Ribonucleotide reductase large subunit; ribonucleotide reductase M1 polypeptide; ribonucleotide reductase, R1 subunit; RIR 1; unnamed protein product
基因别名: PEOB6; R1; RIR1; RnrM1; RR1; RRM1
UniProt ID: (Human) P23921, (Mouse) P07742
Entrez Gene ID: (Human) 6240, (Rat) 685579, (Mouse) 20133